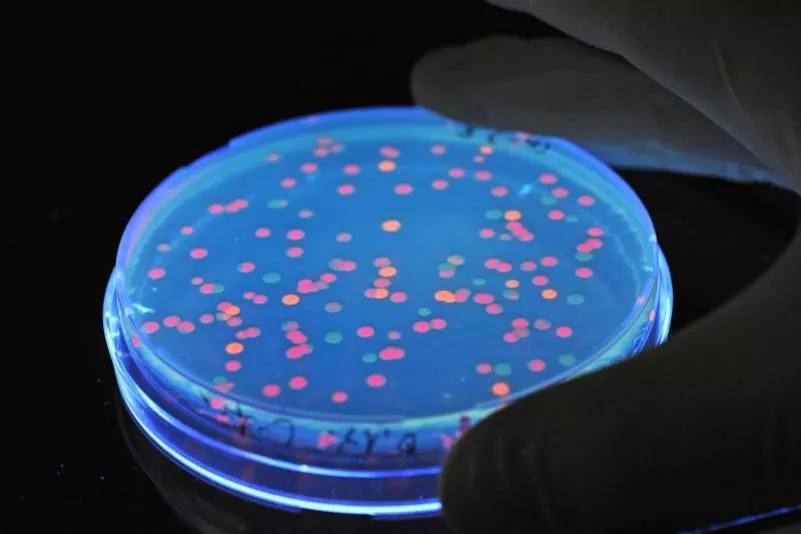
top-article-image

Weiterhin viele gefährliche Darmkeime
Berlin (dpa) - Tierische Keime in Lebensmitteln bleiben in Deutschland ein Problem: Die Zahl der Erkrankungen durch sogenannte Zoonosen sinkt insgesamt nicht. Mehr als 63 600 Menschen zogen sich 2013 eine Darmerkrankung durch Campylobacter zu, 700…
Fluoreszierende Samonellen liegen unter Schwarzlicht im Labor.
Foto: Peter Steffen/Illustration/dpa
Tierische Keime in Lebensmitteln bleiben in Deutschland ein Problem: Die Zahl der Erkrankungen durch sogenannte Zoonosen sinkt insgesamt nicht.
Mehr als 63 600 Menschen zogen sich 2013 eine Darmerkrankung durch Campylobacter zu, 700 mehr als im Vorjahr, berichtete das Bundesinstitut für Risikobewertung (BfR) in seinem Jahresbericht am Mittwoch. Die Zahl der 2013 gemeldeten Salmonellen-Erkrankungen hingegen sank auf etwa 19 000.
Vor allem in Wurst und Fleisch, speziell Geflügel, sind die vom Tier auf den Menschen übertragenen Erreger enthalten. „Die Ergebnisse unseres Berichts unterstreichen, dass die Zoonosenbekämpfung in der Tierhaltung fortgesetzt und bei der Geflügelschlachtung noch intensiviert werden muss“, betonte BfR-Präsident Prof. Andreas Henschel in Berlin.
Oft ist mangelnde Hygiene schuld an der Keimübertragung – etwa, wenn beim Schlachten des Geflügels das Fleisch mit Gefieder oder Darmtrakt in Berührung kommt. Aber auch unzureichende Kühlketten können die Ausbreitung der gefährlichen Darmbakterien fördern.
Als Erfolg wertet das Bundesinstitut, dass die Zahl der Salmonellenfunde in den Lebensmittelproben seit Jahren sinkt. Doch das Darmbakterium Campylobacter breitet sich weiter aus. Vor allem Hühnchenfleisch ist davon betroffen. Lebensmittel- und auch Küchenhygiene seien deshalb sehr wichtig, betonte das BfR.
Andere Erreger, wie Listerien oder bestimmte Ehec-Keime (enterohämorrhagische E. coli-Bakterien), fanden die Kontrolleure deutlich seltener als Campylobacter oder Salmonellen. Jedoch verlaufen die hervorgerufenen Krankheiten beim Menschen oft sehr viel schwerer. 2013 wurden 1621 Ehec-Erkrankungsfälle gemeldet – sechs Prozent mehr als im Vorjahr. Ein großer Teil davon dürfte auf Tiere und tierische Lebensmittel zurückzuführen sein, hieß es. Auf Obst oder Gemüse hingegen wurde 2013 kein Ehec-Erreger nachgewiesen.
Bei dem großen Ausbruch in Deutschland 2011, der mehr 50 Menschen das Leben kostete, waren wahrscheinlich Bockshornklee-Samen aus Ägypten die Quelle, aus denen Sprossen gezüchtet worden waren. Damals grassierte eine besonders aggressive Ehec-Variante.
(dpa)
Kommentare
Noch keine Kommentare – schreiben Sie den ersten Kommentar zu diesem Artikel.
0
Kommentare
Noch keine Kommentare – schreiben Sie den ersten Kommentar zu diesem Artikel.





